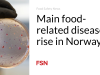
Penyakit utama yang berhubungan dengan makanan meningkat di Norwegia

Hakim Lancaster yang mengawasi kasus persidangan perdata Amos Miller telah memutuskan untuk tidak secara eksplisit membatasi penjualan petani Amish ke luar negara bagian, dengan mengatakan bahwa dia tidak akan menganggap hukum Pennsylvania bersifat ambigu terhadap Miller.
Hasilnya adalah Miller mungkin bebas menjual susu mentahnya yang diproduksi di Pennsylvania ke luar negara bagian.
Keputusan Hakim Daerah Thomas Sponaugle di Departemen Pertanian Pennsylvania (PDA) V. Amos dan Rebecca Miller diambil setelah serangkaian argumen pembelaan oleh pengacara keluarga Miller, Bradford L. Geyer dan Robert E. Barnes.
Hakim berusaha mengklarifikasi perintahnya tanggal 19 Maret, yang melarang penjualan Miller di Pennsylvania tetapi tidak di luar perbatasannya.
PDA telah meminta pengadilan untuk membatasi susu mentah Miller dan menghentikannya agar tidak didistribusikan ke luar negara bagian.
Hal ini mungkin tidak akan disetujui oleh negara bagian, namun hal ini menunjukkan seberapa jauh jarak keluarga Miller dan negara bagian mereka satu sama lain. Hakim mengatakan “pengadilan seharusnya tidak menganggap ambiguitas para terdakwa.”
Tidak diketahui berapa banyak pelanggan luar negara bagian yang menjadi pelanggan Miller. Beberapa orang memperkirakan basis pelanggannya mencapai 4.000 hingga 5.000. Seberapa bermanfaatnya tatanan baru ini bagi Miller juga belum diketahui karena ia menandatangani Keputusan Persetujuan federal tahun lalu, yang berjanji untuk mematuhi berbagai undang-undang keamanan pangan federal.
Menjual susu mentah melintasi batas negara bagian tetap ilegal, menurut hukum federal.
Miller muncul di layar radar PDA pada 23 Januari, ketika eggnog yang dibeli di peternakan dikaitkan dengan penyakit yang ditularkan melalui makanan di New York dan Michigan. Kemudian, PAR menemukan Miller melakukan bisnis tanpa izin dan izin negara.
Pennsylvania adalah negara bagian susu mentah dengan sekitar 115 fasilitas berlisensi, yang menutupi masalah negara bagian tersebut dengan Miller, yang memperoleh dokumen rutin untuk melakukan bisnis.
Pengacara Miller mengatakan: “Undang-undangnya jelas: hanya berlaku untuk penjualan kepada pelanggan Pennsylvania di negara bagian tersebut. Sebaliknya, bahasa yang ingin ditambahkan oleh PDA—’dari Persemakmuran’ dan ‘di mana pun pelanggan tinggal’ — tidak ada dalam undang-undang tersebut. Hal itu juga tidak bisa ada secara konstitusional.”
“Undang-undang pangan mengatur akses terhadap pelanggan di Pennsylvania karena hal tersebut merupakan hal yang dipilih oleh badan legislatif dan hal yang diizinkan oleh Konstitusi; undang-undang tersebut tidak mengatur produsen, pengolah, atau pemilik pangan yang dimaksudkan untuk diekspor ke pasar luar negeri,” argumennya. “Pertimbangkan kekacauan tidak masuk akal yang diciptakan oleh amandemen undang-undang PDA yang mereka minta untuk dilakukan oleh pengadilan ini – siapa pun yang bepergian melalui Pennsylvania dengan makanan yang dimaksudkan untuk dijual di luar negara bagian tersebut sekarang tunduk pada yurisdiksi dan pembatasan PDA, sehingga seseorang yang bepergian dari West Virginia melalui Pennsylvania ke negara bagian lain dengan makanan yang dimaksudkan untuk dijual di luar Pennsylvania dapat dihentikan, digeledah, disita, didenda, diperintahkan, dihukum, dan dipenjarakan. Fasilitas produksi, pengolahan, dan pengangkutan makanan untuk diekspor ke luar Pennsylvania—yang mempekerjakan ribuan orang di Pennsylvania—kini akan dilarang dalam semalam dan akan menyadarkan para penjahat. Hal ini bukanlah hal yang diizinkan oleh badan legislatif atau diperbolehkan oleh Konstitusi. Bertentangan dengan klaim PDA, makanan yang dimaksudkan untuk ekspor sudah diatur oleh Kongres, sebagaimana tercermin dalam proses litigasi yang telah dilakukan selama setengah dekade oleh para Tergugat.”
(Untuk mendaftar berlangganan gratis Berita Keamanan Pangan, klik di sini.)